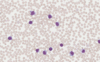
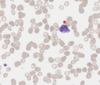
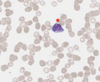
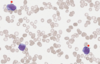
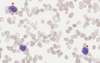

Hvordan er epidemiologien til akutt lymfatisk leukemi (ALL)?

Hvordan er epidemiologien til akutt myeloid leukemi (AML)?

Hvilke etiologi har ALL?

Hvilken etiologi har AML?

Hvordan klassifiserers ALL ved bruk av FAB?

Hvordan klassifiserer ALL jmf. WHO?

Hvordan klassifiserer man ALL basert på immunofenotyping?

Hva viser bildet?


Hva viser bildet?


Hvordan klassifiserer AML jmf. FAB?

Hvordan klassifiserer AML jmf. WHO?

Hva viser bildet?


Hva viser bildet?


Fyll inn figuren


Hvordan er patofysiologien ved akutt leukemi?

Hva er klinikken ved akutt leukemi avhengig av?
Clinical features are either related to bone marrow failure, infiltration of organs by leukemic cells, or a combination of both.
Hvilke generelle kliniske tegn forekommer ved akutt leukemi?

Hvilken klinikk forekommer ved ALL?
Fever and lymphadenopathy are rare in AML, but can be common first signs in ALL!
Remember metastasis for ALL by thinking of the following: ALL metaStaSizeS to the CNS and teSteS.

Hvilken klinikk forekommer ved AML?

Hvordan skal feber hos en pasient med akutt leukemi tolkes?
Fever in a patient with acute leukemia must always be treated as a sign of infection until proven otherwise!
Hva viser bildet?


Hvordan tilnærmer man seg en pas. med mistenkt akutt leukemi?

Hva kan man si om funnene på evt. blodprøver ved akutt leukemi?
Findings on initial laboratory studies are usually nonspecific but may help to identify potentially life-threatening acute complications.
Hvilke funn forekommer ved akutt leukemi av hhv.:
- Leukocytter
- Trombocytter
- Hemoglobin
- Blodutstryk